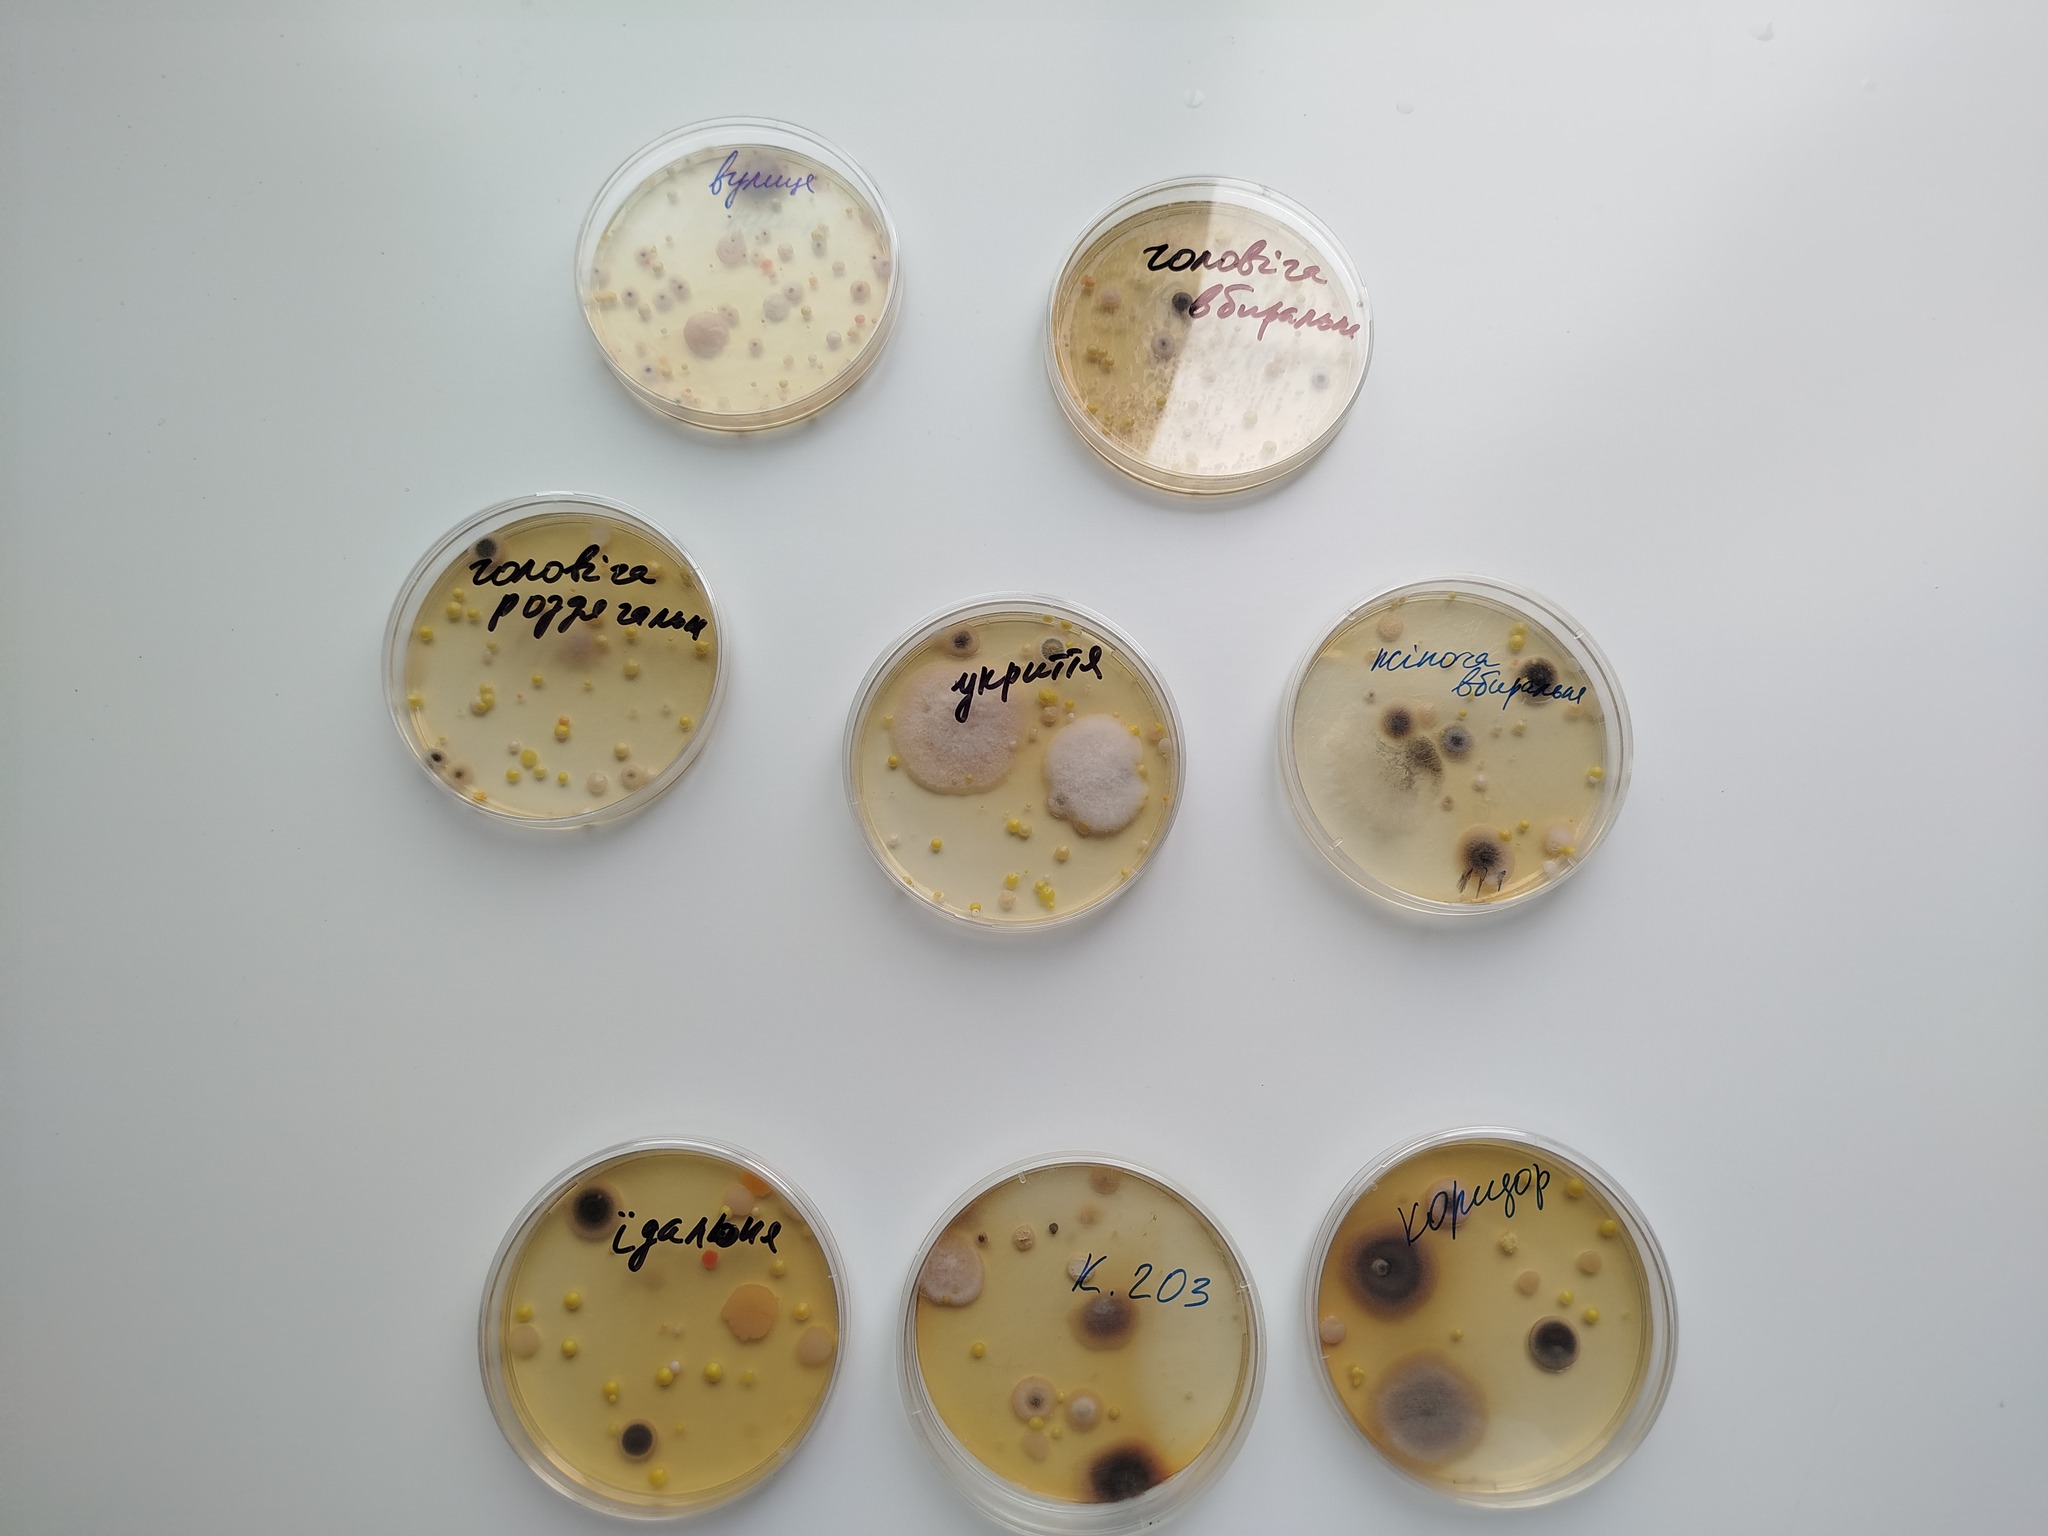

Нещодавно до Інституту завітали учні 10 класу Чернігівського ліцею №1. Для них була організована цікава екскурсія у центральному та лабораторному корпусах. Учні ознайомились із роботою мікробіологів, їхніми науковими дослідженнями, розглянули корисні та патогенні мікроби в пробірках та через мікроскоп в лабораторії пробіотиків.Завідувачка сектору колекції корисних ґрунтових мікроорганізмів Юлія Воробей представила учням основні групи корисних мікроорганізмів, які є в Колекції. Екскурсанти продивились результати досліджень резистентності штамів до антибіотиків. Дізнались про новітні розробки вчених щодо антимікробних речовин, в тому числі за допомогою штучного інтелекту.
Напередодні екскурсії відбувся цікавий експеримент. Учні зібрали повітря в різних приміщеннях школи, а потім в чашках Петрі проводилось мікробне дослідження повітря, оцінювалась кількість та склад мікроорганізмів.
Родзинкою екскурсії у центральному корпусі стало фотографування в кріслі засновника Інституту В.М. Рево, яке знаходиться в бібліотечному музейному куточку.
В лабораторному корпусі гостей супроводжували аспіранти: голова ради молодих вчених Інституту Тетяна Сасіна та її заступник Володимир Глушаков. Тетяна на заздалегідь підготовлених зразках показала різні штами азотфіксувалних мікроорганізмів як безпосередньо через мікроскоп, так і через підключення його до монітора. А в лабораторії вірусології її завідувач Леонід Решотько та Володимир ознайомили ліцеїстів з роботою електронного мікроскопа.